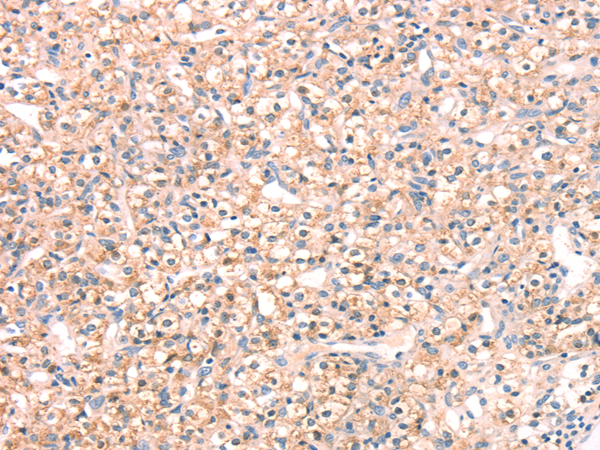
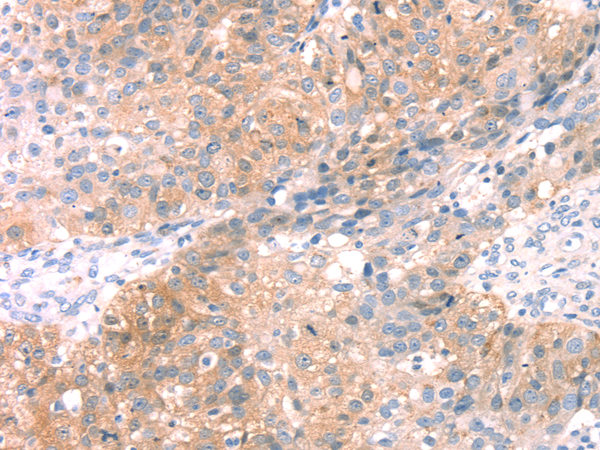
一抗

|
Background: |
Specificity of vesicular transport is regulated, in part, by the interaction of a vesicle-associated membrane protein termed synaptobrevin/VAMP with a target compartment membrane protein termed syntaxin. These proteins, together with SNAP25 (synaptosome-associated protein of 25 kDa), form a complex which serves as a binding site for the general membrane fusion machinery. |
|
Applications: |
ELISA, WB, IHC |
|
Name of antibody: |
SNAP23 |
|
Immunogen: |
Full length fusion protein |
|
Full name: |
synaptosomal-associated protein, 23kDa |
|
Synonyms: |
SNAP-23; SNAP23A; SNAP23B; HsT17016 |
|
SwissProt: |
O00161 |
|
ELISA Recommended dilution: |
5000-10000 |
|
IHC positive control: |
Human prostate cancer and human breast cancer |
|
IHC Recommend dilution: |
25-100 |
|
WB Predicted band size: |
23 kDa |
|
WB Positive control: |
Human placenta tissue and hela cells, hepg2 cells and human fetal liver tissue, A549 cells and human normal kidney tissue |
|
WB Recommended dilution: |
500-2000 |

購物車
購物車 幫助
幫助
 021-54845833/15800441009
021-54845833/15800441009